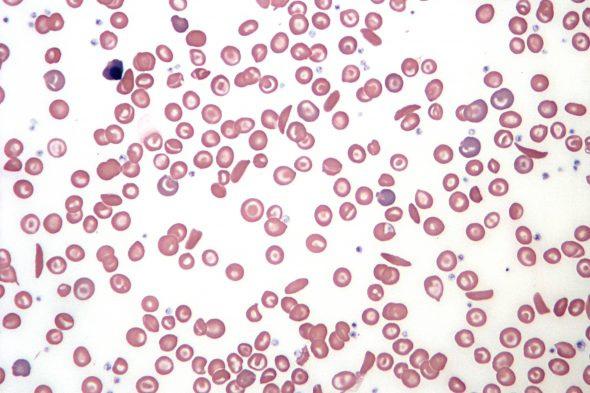

3 minute read
Approves Sickle Cell Treatments, Including One That Uses CRISPR
By: Zaiyi


Recently, the Food and Drug Administration (FDA) approved the first gene editing therapy ever to be used in humans, which could be potentially revolutionizing treatment for people with sickle cell disease (a debilitating blood disorder caused by a mutated gene).
While this new treatment may alleviate pain and suffering for lives across America, this treatment is expensive and difficult. Although families find reassurance in its FDA approval, the obstacles that come with this treatment are not minimal Only a small select number of medical centers are authorized to provide it, along with a multimillion-dollar price range to develop and operate, and potential insurance problems. Not everyone can tolerate this treatment, as each patient’s cells must be edited or have a gene added individually. “It is practically a miracle that this is even possible,” said Dr. Stephan Grupp, chief of the cellular therapy and transplant section at Children’s Hospital of Philadelphia As a result, only about 20,000 patients will be eligible for this treatment (1)
The gene editing treatment, named Exa-cel and marketed as Casgevy, was jointly developed by Vertex Pharmaceuticals of Boston and CRISPR Therapeutics of Switzerland.
It uses CRISPR, the Nobel Prize-winning gene editing tool, to snip patients’ DNA (2) For a tiny number of patients in clinical trials, it fixed the effects of the mutation This results in red blood cells that become caught in blood vessels, blocking them. Casgevy is the first treatment to be approved that uses CRISPR. Anothertreatment, that goes by the name of Lyfgenia, is made by Bluebird Bio of Somerville, Massachusetts. Lyfgenia uses a gene therapy method to add healthy hemoglobin genes to patients’ DNA (1)
Treatment begins with hospital visits to collect patients’ bone marrow stem cells; the precursors of red blood cells that are treated to allow the production of healthy blood cells. Stem cells must be released from the marrow into the blood so they can be collected. To release them, doctors inject patients with a drug called Plerixafor. After editing a patient’s cells with CRISPR, technicians do a sequence of quality checks
About 16 weeks after the process begins, the cells will be shipped back to the medical center to be infused into the patient So far, Vertex has nine centers to provide its treatment. The company says it will eventually expand to about 50. Bluebird has 27 authorized centers and also has plans to add more (1).





Patients who hear about this new treatment are eager to get on the list to receive it. The Children’s Hospital of Philadelphia, among others, is hoping to get on Vertex’s list of approved centers and is planning to take eligible patients on a first-come-first-served basis Others, like the Children’s National Hospital in Washington, will give priority to the sickest patients. Dr. Azar, a hematologist at Massachusetts General, proposes a more cautious approach if approved starting with just one patient experiencing the full treatment first. He has concerns that a misstep could do more harm than good (1)
Moving forward, the therapies will be provided without the extensive support that the companies gave to clinical trial participants. It will be a test case for using CRISPR gene editing to treat other diseases. CRISPR Therapeutics is now studying gene editing to treat cancer, diabetes, and A.L.S., among others. “It is a blessing and curse that we are going first,” Dr. Azar said. “Sickle cell disease has never been first for anything” (1)
Works Cited